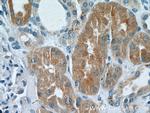
DAB2 Antibody in Immunohistochemistry (Paraffin) (IHC (P))

Search
Proteintech
DAB2 Polyclonal Antibody
{{$productOrderCtrl.translations['antibody.pdp.commerceCard.promotion.promotions']}}
{{$productOrderCtrl.translations['antibody.pdp.commerceCard.promotion.viewpromo']}}
{{$productOrderCtrl.translations['antibody.pdp.commerceCard.promotion.promocode']}}: {{promo.promoCode}} {{promo.promoTitle}} {{promo.promoDescription}}. {{$productOrderCtrl.translations['antibody.pdp.commerceCard.promotion.learnmore']}}
产品信息
10109-2-AP
种属反应
已发表种属
宿主/亚型
分类
类型
抗原
偶联物
形式
浓度
规格
纯化类型
保存液
内含物
保存条件
运输条件
产品详细信息
Immunogen sequence: VDYFGQQFD QISNRTGKQE AQAGPWPFSS SQTQPAVRTQ NGVSEREQNG FSVKSSPNPF VGSPPKGLSI QNGVKQDLES SVQSSPHDSI AIIPPPQSTK PGRGRRTAKS SANDLLASDI FAPPVSEPSG QASPTGQPTA LQPNPLDLFK TSAPAPVGPL VGLGGVTVTL PQAGPWNTAS LVFNQSPSMA PGAMMGGQPS GFSQPVIFGT SPAVSGWNQP SPFAASTPPP VPVVWGPSAS VA (340-580 aa encoded by BC003064)
靶标信息
DAB2 mRNA is expressed in normal ovarian epithelial cells but is down-regulated or absent from ovarian carcinoma cell lines. The 770-amino acid predicted protein has an overall 83% identity with the mouse p96 protein, a putative mitogen-responsive phosphoprotein; homology is strongest in the amino-terminal end of the protein in a region corresponding to the phosphotyrosine interaction domain. The down-regulation of DAB2 may play an important role in ovarian carcinogenesis. This gene was initially named DOC2 (for Differentially expressed in Ovarian Cancer) and is distinct from the DOC2A and DOC2B genes (for double C2-like domains, alpha and beta).
仅用于科研。不用于诊断过程。未经明确授权不得转售。
生物信息学
蛋白别名: Adaptor molecule disabled-2; Dab, mitogen-responsive phosphoprotein, homolog 2; DAB2, clathrin adaptor protein; Differentially expressed in ovarian carcinoma 2; Differentially-expressed protein 2; Disabled homolog 2; disabled homolog 2, mitogen-responsive phosphoprotein; DOC-2; FLJ26626; mitogen responsive phosphoprotein; unnamed protein product
基因别名: DAB2; DOC-2; DOC2
UniProt ID: (Human) P98082
Entrez Gene ID: (Human) 1601